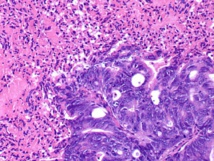
Células tumorales en un cáncer de páncreas. Fuente: Universidad de Michigan (EEUU). Células tumorales en un cáncer de páncreas. Fuente: Universidad de Michigan (EEUU).

Las diferencias que existen entre las células sanas y las células tumorales de un mismo organismo son el punto de partida de un nuevo modelo matemático creado por los investigadores del Moffitt Cancer Center de Florida, EEUU.
El medio en que se desarrollan los tumores es, en comparación, mucho más ácido que el medio de un tejido normal, pues las células tumorales “consumen más glucosa y segregan ácidos como producto de desecho”, afirma el doctor Mark Robsertson-Tessi, investigador del Departamento de Oncología Matemática Integrada de Moffitt.
Partiendo de esta base, las diferencias que se pueden observar dentro del propio tumor son similares. El metabolismo de la glucosa es mayor en la zona central del tumor, y la producción de ácidos se reduce en las zonas exteriores. La consecuencia de esto es que las células centrales sean mucho más agresivas y tiendan a expandirse hacia fuera, dando así lugar al comportamiento invasivo del tumor.
Necesidad de tratamientos diferenciados
Para demostrar esta característica de los tumores, la investigación de Moffitt ha desarrollado un modelo matemático que predice las interacciones tanto del tumor con su entorno sano, como de las células propiamente cancerosas entre sí. El modelado permitirá demostrar cómo afectarán al desarrollo del tumor las diferentes terapias que se le apliquen.
La principal consecuencia que se desprende del estudio es que es necesario conocer bien estas predicciones de crecimiento para aplicar el tratamiento más adecuado. El conocimiento de los mecanismos internos del tumor permitirá evitar terapias que han demostrado ser incluso contraproducentes; es el caso de la terapia antiangiogénica, que bloquea el crecimiento de nuevos vasos sanguíneos –una de las principales fuentes de alimento para las células tumorales- pretendiendo así bloquear el crecimiento tumoral.
En la práctica, sin embargo, la terapia ha demostrado que no solo no es efectiva, sino que puede resultar contraproducente. Al atacar las células más exteriores del tumor, las del interior de este, más agresivas, tienen “vía libre” para actuar y extender el cáncer. Al menos, eso es lo que los investigadores creen que se desprende de los resultados de este nuevo modelo.
El medio en que se desarrollan los tumores es, en comparación, mucho más ácido que el medio de un tejido normal, pues las células tumorales “consumen más glucosa y segregan ácidos como producto de desecho”, afirma el doctor Mark Robsertson-Tessi, investigador del Departamento de Oncología Matemática Integrada de Moffitt.
Partiendo de esta base, las diferencias que se pueden observar dentro del propio tumor son similares. El metabolismo de la glucosa es mayor en la zona central del tumor, y la producción de ácidos se reduce en las zonas exteriores. La consecuencia de esto es que las células centrales sean mucho más agresivas y tiendan a expandirse hacia fuera, dando así lugar al comportamiento invasivo del tumor.
Necesidad de tratamientos diferenciados
Para demostrar esta característica de los tumores, la investigación de Moffitt ha desarrollado un modelo matemático que predice las interacciones tanto del tumor con su entorno sano, como de las células propiamente cancerosas entre sí. El modelado permitirá demostrar cómo afectarán al desarrollo del tumor las diferentes terapias que se le apliquen.
La principal consecuencia que se desprende del estudio es que es necesario conocer bien estas predicciones de crecimiento para aplicar el tratamiento más adecuado. El conocimiento de los mecanismos internos del tumor permitirá evitar terapias que han demostrado ser incluso contraproducentes; es el caso de la terapia antiangiogénica, que bloquea el crecimiento de nuevos vasos sanguíneos –una de las principales fuentes de alimento para las células tumorales- pretendiendo así bloquear el crecimiento tumoral.
En la práctica, sin embargo, la terapia ha demostrado que no solo no es efectiva, sino que puede resultar contraproducente. Al atacar las células más exteriores del tumor, las del interior de este, más agresivas, tienen “vía libre” para actuar y extender el cáncer. Al menos, eso es lo que los investigadores creen que se desprende de los resultados de este nuevo modelo.
La importancia de las matemáticas
Para Alexander Anderson, miembro del Departamento de Oncología Matemática Integrada de Moffitt, “solo mediante la integración de modelos matemáticos y computacionales con una cuidadosa experimentación podemos unir los estudios del crecimiento del cáncer centrados en la genética y el entorno”.
No es la única opinión que defiende el uso de las matemáticas para la lucha contra el cáncer, y que cada día es mayor. Desde que en 2004 se publicara un estudio que demostraba que el crecimiento de las células tumorales podía compararse al modelado de fractales, este tipo de investigaciones han abundado.
A principios de 2015, por ejemplo, científicos del Kimmel Cancer Center de la Universidad Johns Hopkins de EEUU demostraron que en el desarrollo de estas enfermedades jugaba un papel más importante el surgimiento de mutaciones azarosas (un 65% de las veces) que la genética o los factores ambientales.
En este sentido, quizás el estudio más importante sea el que realizara la Universidad de Harvard en 2013, afirmando que eran necesarios modelos matemáticos para estudiar la genética de cada paciente, y desarrollar así terapias basadas en la combinación de varios medicamentos.
El nuevo modelo de Moffitt, combinado con estudios como el de Harvard, permitirá una mejor respuesta contra la enfermedad, al conocer las características concretas del crecimiento tumoral y las características genéticas de los pacientes.
Para Alexander Anderson, miembro del Departamento de Oncología Matemática Integrada de Moffitt, “solo mediante la integración de modelos matemáticos y computacionales con una cuidadosa experimentación podemos unir los estudios del crecimiento del cáncer centrados en la genética y el entorno”.
No es la única opinión que defiende el uso de las matemáticas para la lucha contra el cáncer, y que cada día es mayor. Desde que en 2004 se publicara un estudio que demostraba que el crecimiento de las células tumorales podía compararse al modelado de fractales, este tipo de investigaciones han abundado.
A principios de 2015, por ejemplo, científicos del Kimmel Cancer Center de la Universidad Johns Hopkins de EEUU demostraron que en el desarrollo de estas enfermedades jugaba un papel más importante el surgimiento de mutaciones azarosas (un 65% de las veces) que la genética o los factores ambientales.
En este sentido, quizás el estudio más importante sea el que realizara la Universidad de Harvard en 2013, afirmando que eran necesarios modelos matemáticos para estudiar la genética de cada paciente, y desarrollar así terapias basadas en la combinación de varios medicamentos.
El nuevo modelo de Moffitt, combinado con estudios como el de Harvard, permitirá una mejor respuesta contra la enfermedad, al conocer las características concretas del crecimiento tumoral y las características genéticas de los pacientes.
Referencia bibliográfica:
M. Robertson-Tessi, R. J. Gillies, R. A. Gatenby, A. R. Anderson. Impact of Metabolic Heterogenety on Tumor Growth, Invasion and Treatment Outcomes. Cancer Research (2015). DOI: 10.1158/0008-5273.CAN-14-1428.
M. Robertson-Tessi, R. J. Gillies, R. A. Gatenby, A. R. Anderson. Impact of Metabolic Heterogenety on Tumor Growth, Invasion and Treatment Outcomes. Cancer Research (2015). DOI: 10.1158/0008-5273.CAN-14-1428.

Tendencias Científicas

El corazón débil también daña al cerebro
CIENCIA ON LINE